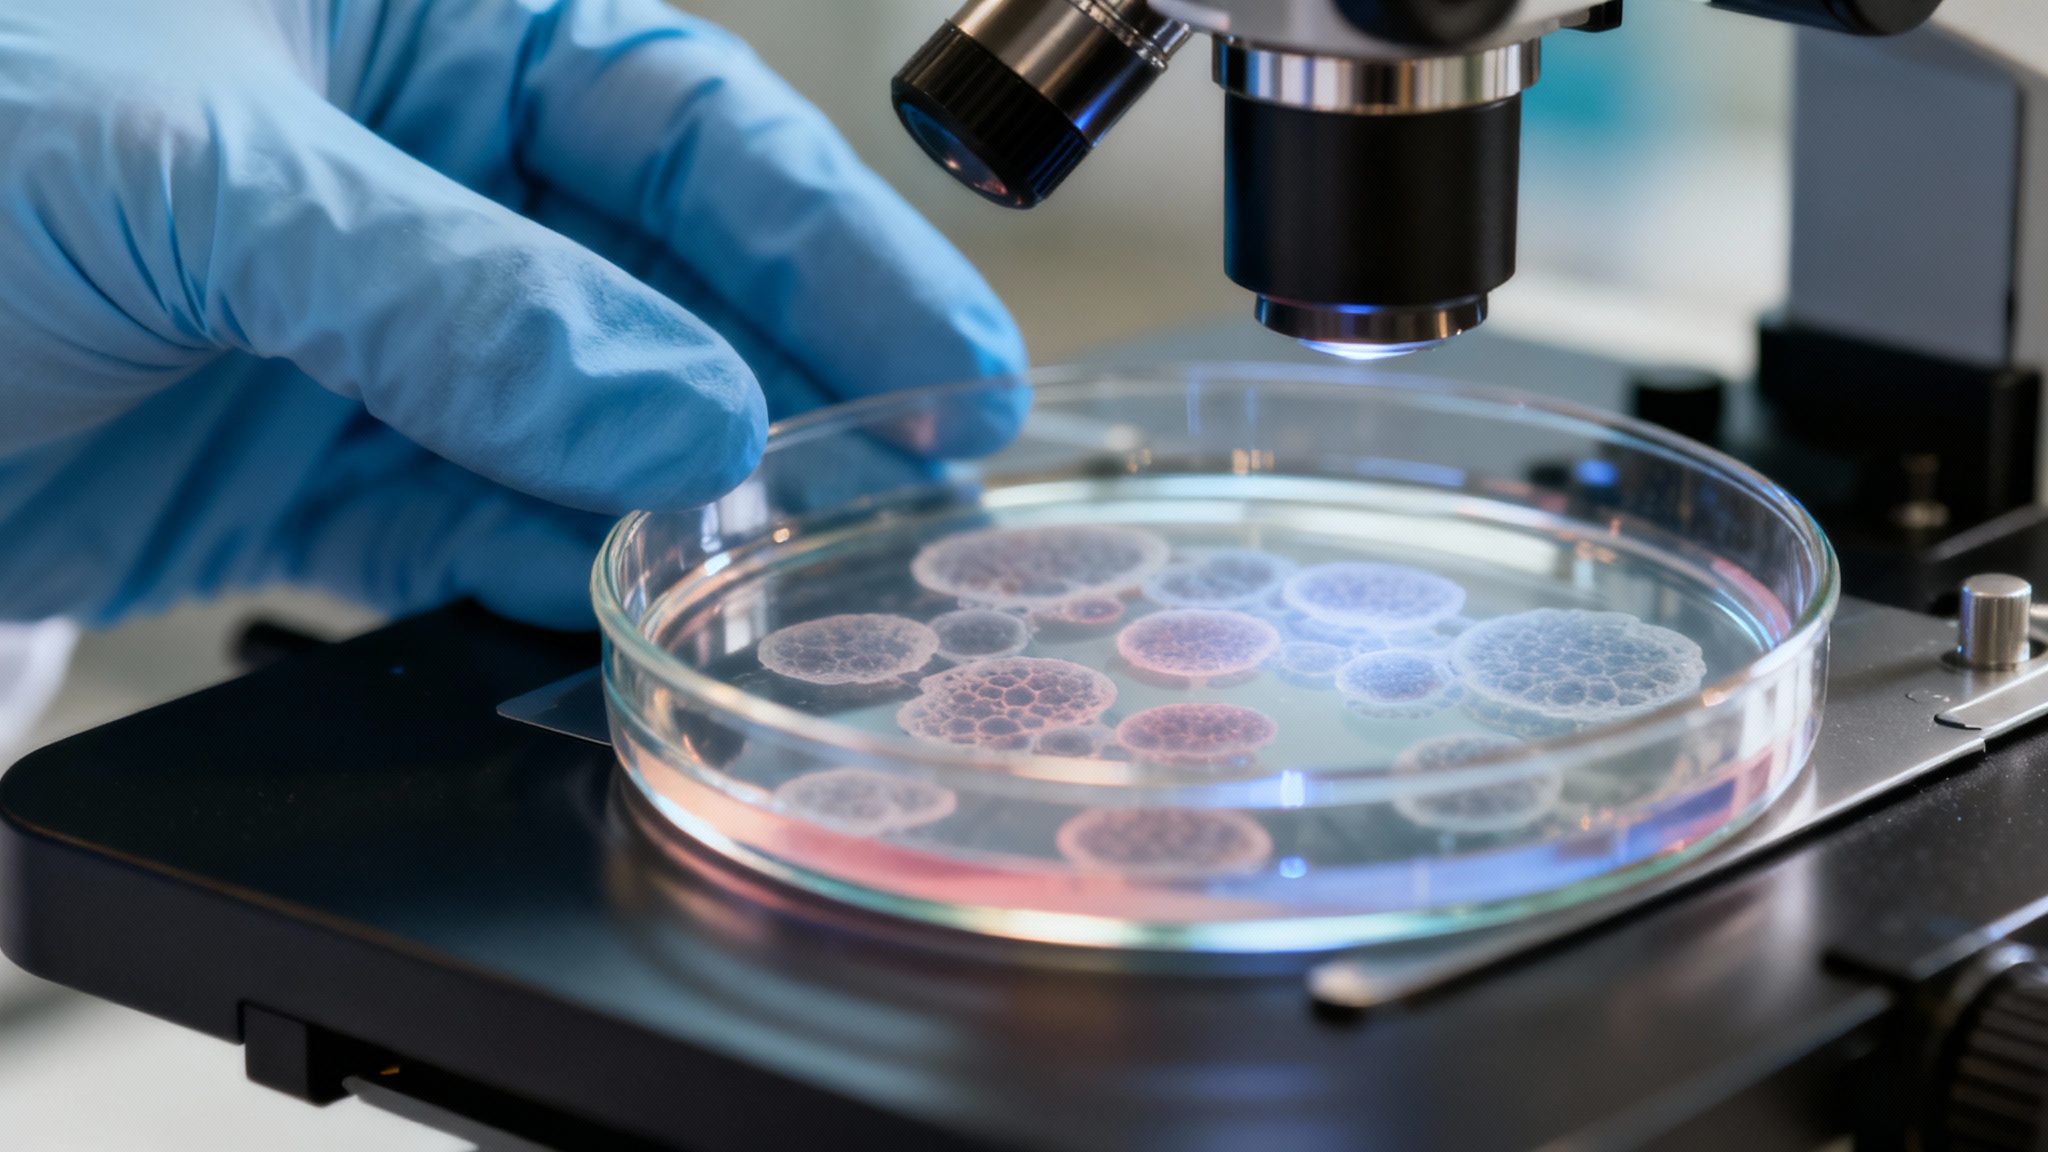
Leucémie : des chercheurs percent le secret des cellules qui refusent de mourir

Un ennemi redoutable nommé LAM

Pourtant, un obstacle majeur se dresse systématiquement : après un certain temps, les cellules leucémiques développent une résistance, comme si elles apprenaient à contourner l’attaque. C’est cette énigme que les scientifiques de l’Université Rutgers ont entrepris de résoudre.
Au cœur du sabotage : les mitochondries transformées en forteresses

Sous l’effet d’une surexpression de la protéine OPA1, les crêtes internes des mitochondries se resserrent, formant une sorte de cage moléculaire. Cette structure modifiée piège le cytochrome c, une molécule dont la libération est le signal de départ de l’autodestruction. En résumé, la cellule cancéreuse transforme ses propres organites en forteresses pour empêcher l’ordre de « suicide » d’être exécuté.
La preuve par la souris

Lorsqu’ils sont administrés en combinaison avec le vénétoclax, ces inhibiteurs ont tout simplement doublé la durée de survie des souris par rapport à celles ne recevant que le traitement standard. Fait remarquable, cette approche s’est révélée efficace y compris contre des sous-types de leucémie connus pour leur extrême résistance, notamment ceux porteurs d’une mutation du gène p53.
Une stratégie à double détente

L’autre bonne nouvelle, c’est que ces composés semblent épargner les cellules saines. Lors des essais sur les souris, la production normale de cellules sanguines n’a pas été affectée, un point crucial pour tout futur traitement.
Conclusion : bien plus qu'une simple leucémie

En comprenant comment les cellules cancéreuses s’accrochent à la vie, la science nous donne peut-être enfin les moyens de leur couper les vivres. Un pas de géant dans la lutte contre la résistance aux traitements, ce mur contre lequel butent encore trop souvent médecins et patients.
Selon la source : trustmyscience.com










